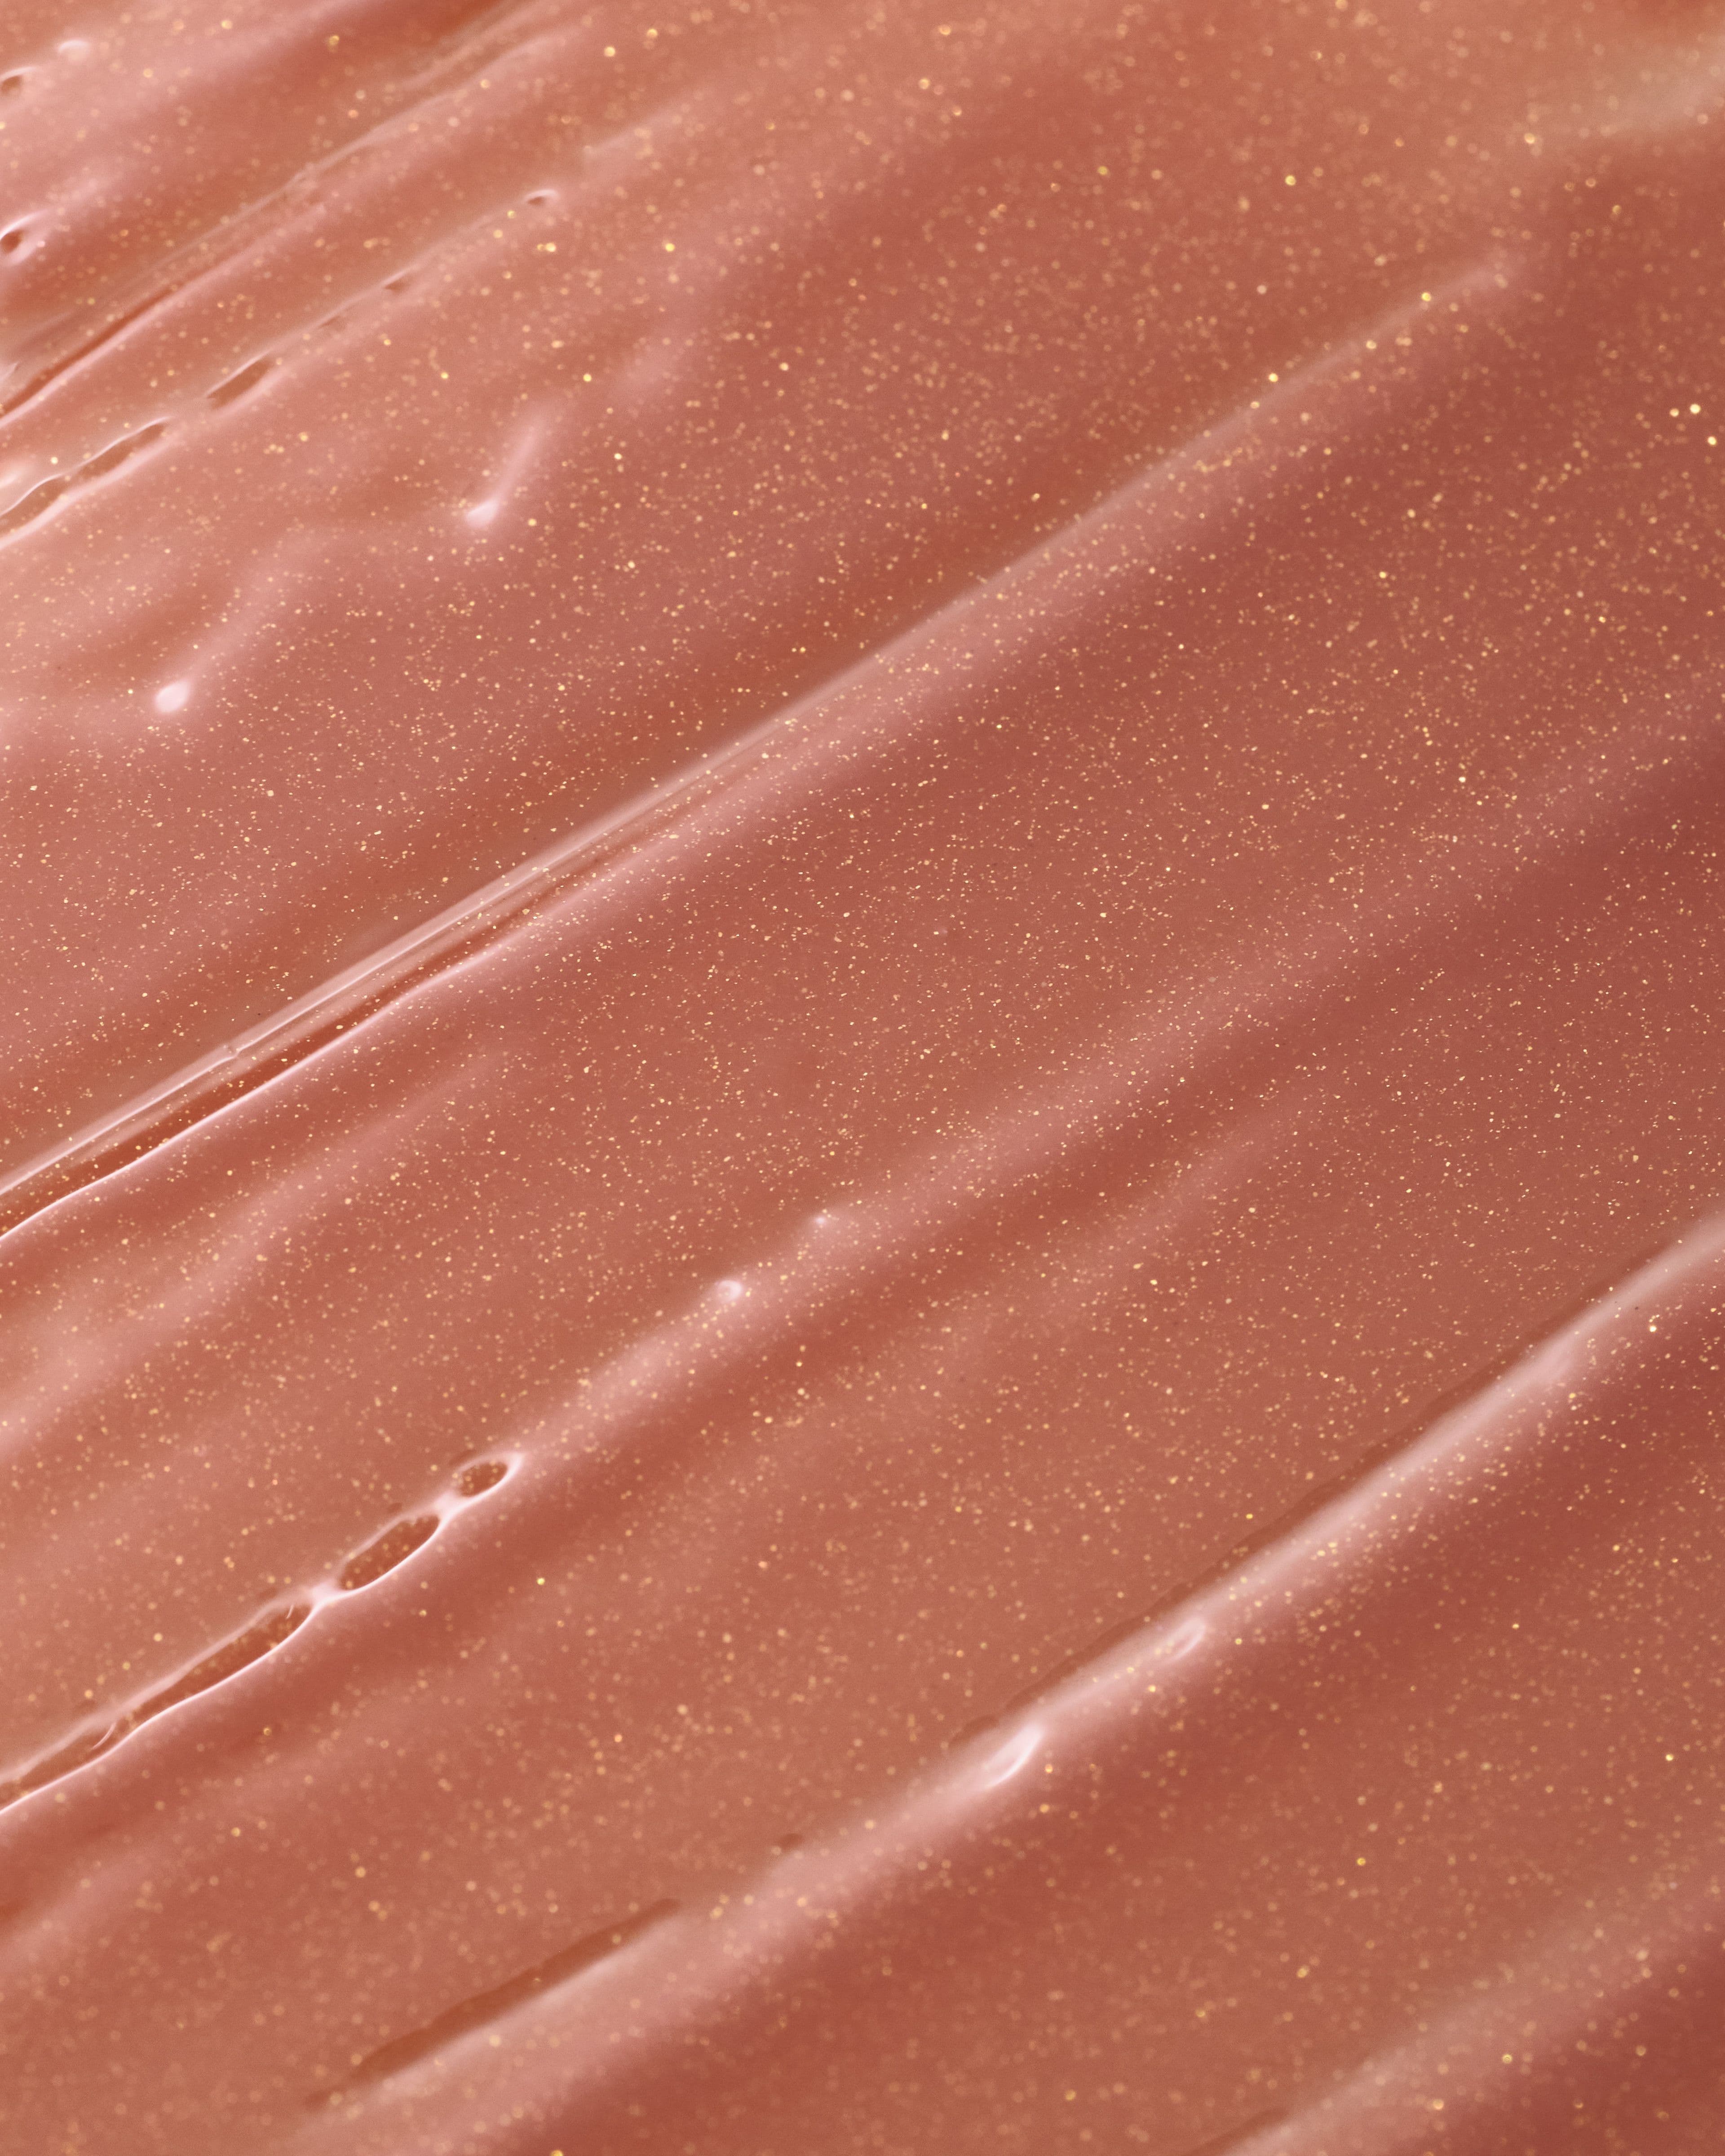
Amazing Aroma - Image 3

Amazing Aroma
Повний цикл створення фото- та відеоконтенту для парфумерного бренду: від каталожних зйомок до креативних композицій і рекламних відео.

Amazing Aroma — наш постійний клієнт, для якого ми вже кілька років системно закриваємо більшість потреб у візуальному контенті. Співпраця побудована як довгострокове партнерство.






У рамках проєкту ми реалізуємо різні типи зйомок:
— каталожні фото для сайту та маркетплейсів
— композиційні предметні зйомки для соцмереж і реклами
— контент для публікацій у медіа та журналах
— предметні відео
— зйомки з моделями для передачі настрою та емоцій бренду
— контент для нових запусків
Ми працюємо з продуктом на всіх рівнях — від базової презентації до складних креативних концепцій. Завдяки цьому бренд отримує не просто набір матеріалів, а системний, впізнаваний і масштабований візуал, який працює в різних каналах: від сайту до рекламних кампаній.
Такий підхід дозволяє забезпечити стабільну якість контенту, швидко адаптуватися під нові задачі та підтримувати єдину стилістику бренду у всіх точках контакту з аудиторією.